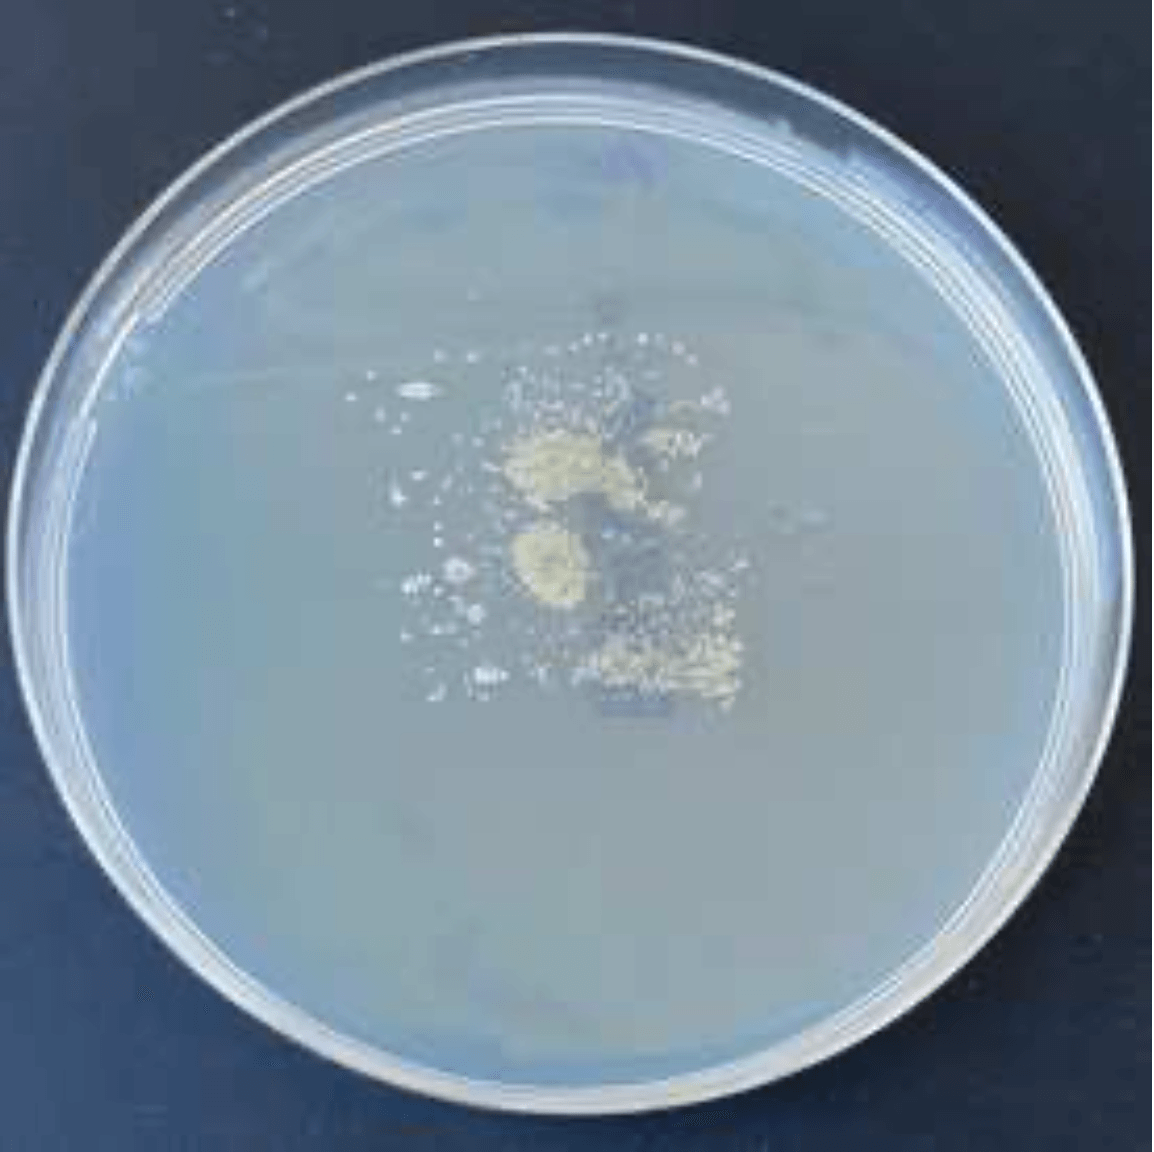
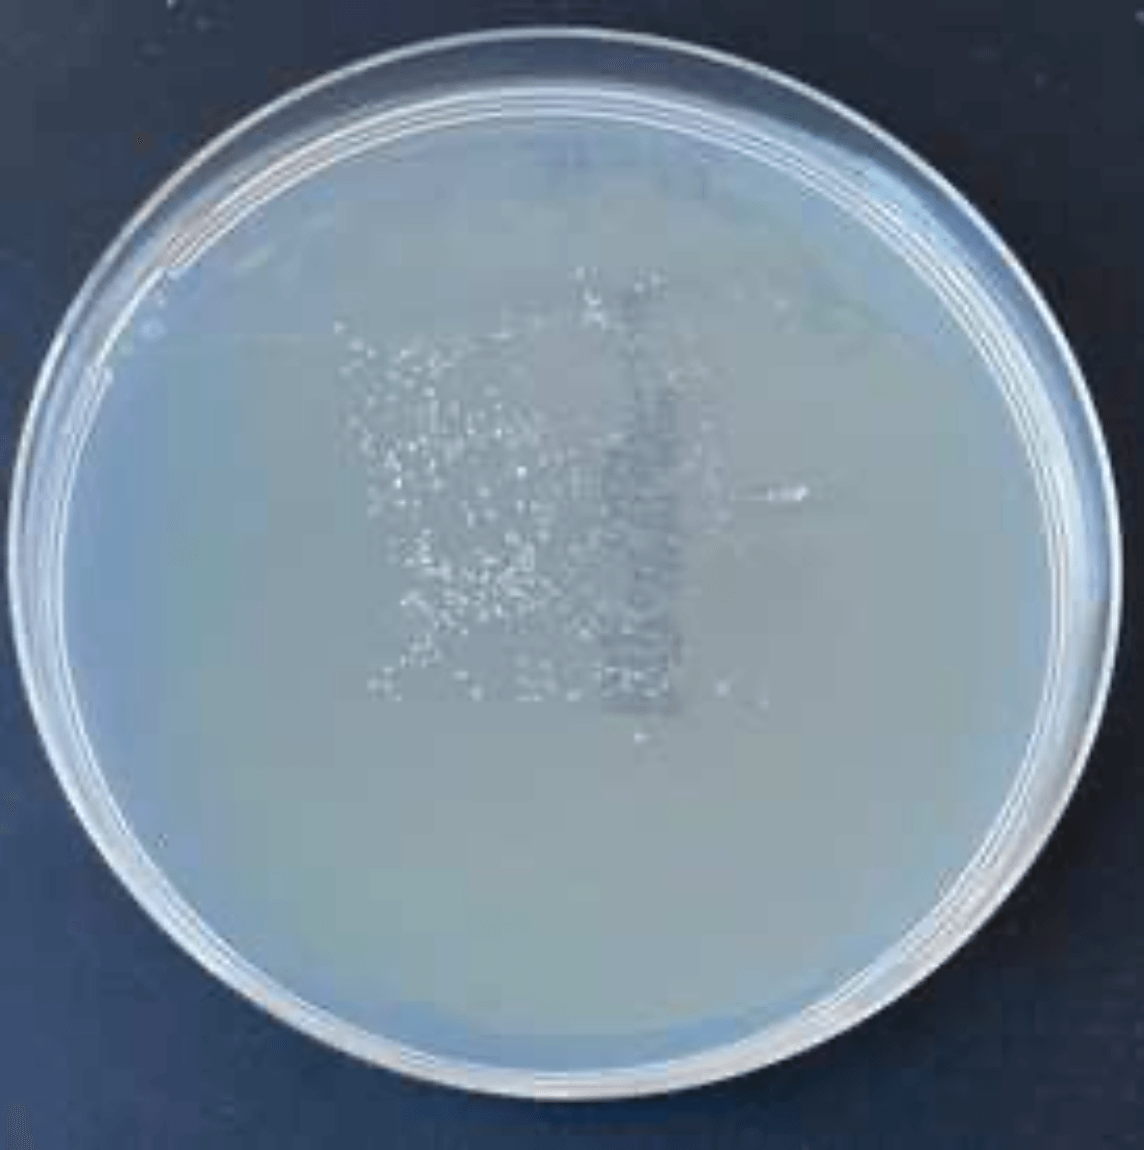
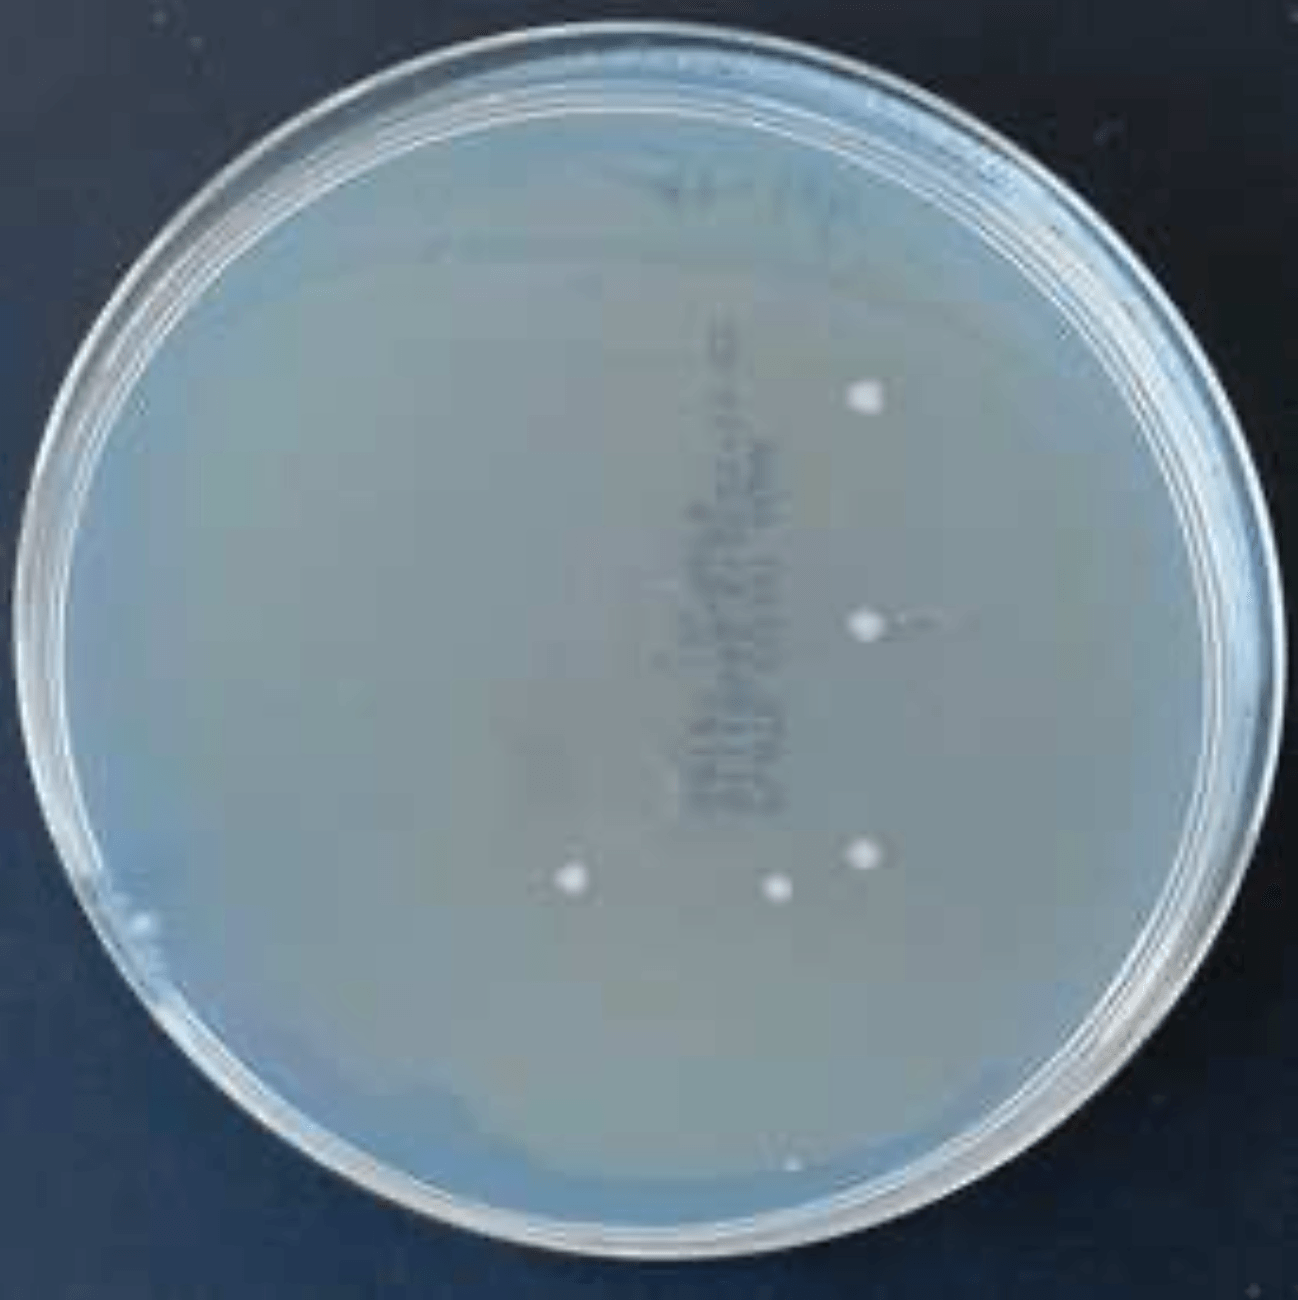
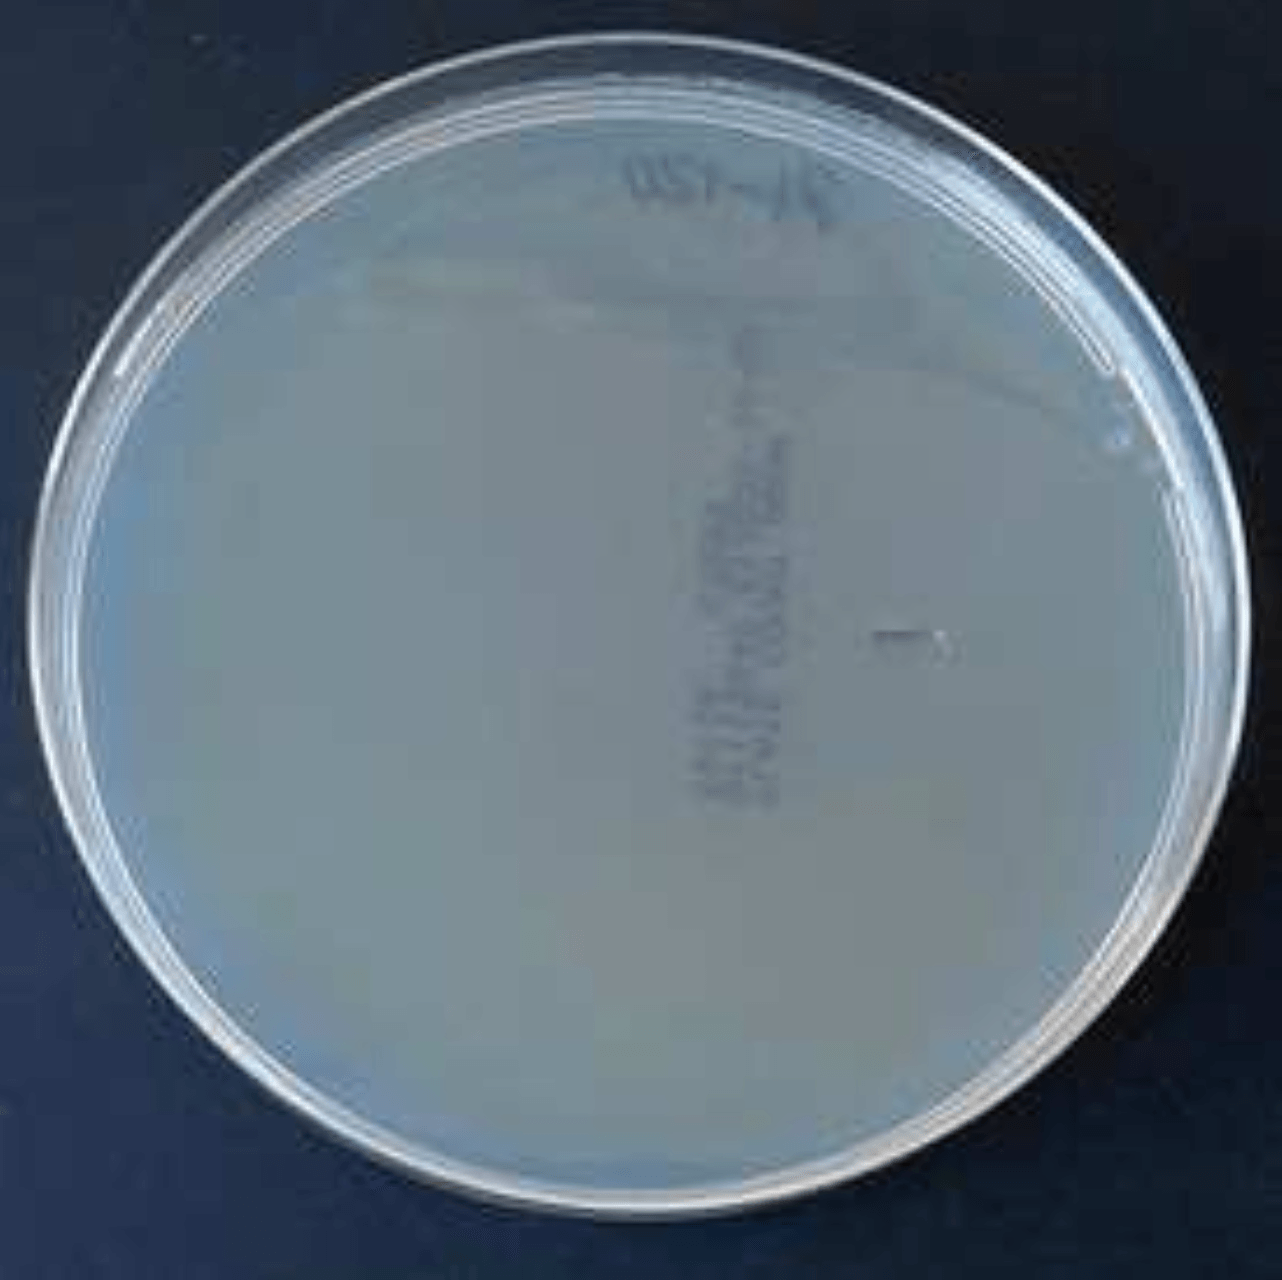

itHygieneProtect
das problem mit bakterien und viren
Der Kampf gegen Viren und multiresistente Erreger ist von lebenswichtiger Bedeutung. In Einrichtungen der Alten- und Krankenversorgung stellen multiresistente Bakterien sowie Coronaviren und MRSA eine besondere Gefahr dar. Hauptsächlich betroffen sind die operativen Intensivstationen, Abteilungen für Brandverletzungen und Neugeborenen-Stationen. Aber auch in Alten- und Pflegeheimen, ambulanten Diensten, öffentlichen Duschen bis hin zu Kirchen und Privathaushalte befinden sich diese Erreger. Diese Erreger liegen tage- und wochenlang auf allen Oberflächen (Coronaviren sind auf Oberflächen bis zu 28 Tage infektiös!) und können durch Berührung übertragen werden.
Oberflächen müssen daher regelmäßig desinfiziert werden. Dies hilft jedoch nur bis zur nächsten Kontamination, die bereits durch die nächste Berührung erfolgen kann. Hier setzt die viruzide und bakterizide Beschichtung
itHygieneProtect an.
unser ziel
Wir unterbrechen die Infektionskette, indem Oberflächen durch unseren Lack keimfrei gemacht werden und das Infektionsrisiko durch eine Schmierinfektion auf Oberflächen verringert wird!
DIE LÖsung
itHygieneProtect
itHygieneProtect ist eine einfach aufzutragende, dünnschichtige und transparente Beschichtung für nahezu alle glatten Oberflächen. itHygieneProtect unterbricht dauerhaft die Infektionsketten durch die Abtötung von 99% der Bakterien und Viren mit Hüllen wie Influenza und Corona innerhalb kürzester Zeit. Somit sind die Oberflächen auch nach und zwischen den Reinigungs- und Desinfektionszyklen geschützt.
Warum itHygieneProtect?
Dauerhafter Schutz für Oberflächen gegen Schmierinfektionen durch Bakterien und Viren bis zu 3 Jahre
Sofort einsetzende Wirkung - Reduziert 99% der Bakterien und Viren innerhalb von 30 Minuten auf Oberflächen
Geprüft und bestätigt durch die unabhängigen Prüfinstitute EUROVIR® & MTC. Registriert bei der Bundesanstalt für Arbeitsschutz und Arbeitsmedizin
Erforscht von einem Forscherteam aus Gronau, Germany
Einfach aufzutragende, transparente, dünnschichtige, beständige sowie geruchlose Beschichtung
Einsparung von Reinigungsmitteln und Reinigungskräfte - Oberflächen lassen sich mit milden Mitteln oder Wasser reinigen
Reduzierung der Umweltbelastung -
Einsparungen von Desinfektionsmitteln, Halogenfrei, kein freies Chlor, Brom oder Flour
UNSERE PRODUKTE
itCoating H 610 N
✔︎ Biologisch aktiv - antibakteriell und antiviral
✔︎ Dauerhafter Schutz
✔︎ Einfach aufzutragen durch Wischen
✔︎ Ergiebigkeit: 1l für ca. 40-50m2
✔︎ 20-30 Minuten Trockenzeit
itCoating K 620 V
✔︎ Biozid-freie, Viren- und Bakterien-abweisende Schutzschicht
✔︎ Porendichte Oberfläche
✔︎ Dauerhafter Schutz - Doppelte Haltbarkeit
✔︎ Einfach aufzutragen durch Wischen
✔︎ Ergiebigkeit: 1l für ca. 70-90m2
✔︎ 60-90 Minuten Trockenzeit
✔︎ (Desinfizierende) Lösungsmittel
itCoating K 630 N
✔︎ Biologisch aktiv - antibakteriell und antiviral
✔︎ Porendichte Oberfläche
✔︎ Viren- und Bakterienabweisende Schutzschicht
✔︎ Dauerhafter Schutz - Doppelte Haltbarkeit
✔︎ Einfach aufzutragen durch Wischen
✔︎ Ergiebigkeit: 1l für ca. 70-90m2
✔︎ 60-90 Minuten Trockenzeit
✔︎ (Desinfizierende) Lösungsmittel
THAT'S IT Lacktuch
✔︎ Beseitigt 99% der Bakterien und Viren
✔︎ Dauerhafter Schutz bis zu 12 Monate
✔︎ Transparenter, dünnschichtiger, geruchloser, nicht fühlbarer Lack
✔︎ Einfach aufzutragen durch Wischen
✔︎ Für ca. 10 Türklinken oder 10 Meter Handlauf
✔︎ 20-30 Minuten Trockenzeit
GRIPS® Antikeimfolie
✔︎ Beseitigt 99% der Bakterien und Viren
✔︎ Dauerhafter Schutz bis zu 12 Monate
✔︎ Transparente, selbstklebende 3D-Folie
✔︎ Extrem druck- und kratzbeständig
✔︎ Hochwirksam ohne Verwendung von Silberionen
✔︎ leicht aufzubringen, auch auf unebenen Oberflächen und Griffen
✔︎ in verschiedenen Größen erhältlich
Wirksamkeit bestätigt!
itHygieneProtect
besitzt neben seiner bakteriziden Wirkung auch eine systematische Wirksamkeit gegen die Familie der Coronaviren, zu denen auch Influenza A Virus H1N1 und COVID-19 (SARS-CoV-2) gehören und gibt dadurch einen zusätzlichen Schutz vor Schmierinfektion durch häufig berührte Oberflächen wie Türklinken, Handgriffen, Theken etc. Gerade gegen behüllte Viren, zu denen die Klasse der Coronaviren gehören, konnte eine beschleunigte Abnahme der Keime nachgewiesen werden. Unsere Produkte haben nachfolgende Prüfungen und Tests, durchgeführt von den unabhängigen Prüfinstitute EUROVIR® & Dr. Brünke MTC - Microbiological Testing Competence
bestanden hat:
| Wirkt gegen Bakterien und Viren... | …die folgende Krankheiten verursachen können… | ...sind auf Oberflächen infektiös bis zu | >99%-ige Reduzierung innerhalb |
|---|---|---|---|
| Staphylococcus aureus | Lungenentzündungen | 7 Monate | 15 Minuten |
| Staphylococcus aureus MRSA | Lungenentzündungen | 7 Monate | 15 Minuten |
| Escherichia coli | Durchfallerkrankungen | 16 Monate | 15 Minuten |
| Influenza A Virus H1N1 | Grippeerkrankungen | 1-2 Tage | 30 Minuten |
| Bovinen Coronavirus | Lungenentzündungen | 9 Tage | 30 Minuten |
exklusive bilder aus dem labor
Wirkung von itCoating H 610 N gegen Bakterien Staphylococcus aureus:
In den ersten Sekunden
Nach 15 Minuten
Nach 2 Stunden

Wirkung von itCoating H 610 N gegen Bakterien Escherichia coli:
In den ersten Sekunden

Nach 15 Minuten
Nach 2 Stunden

Wirkung von itCoating H 610 N gegen Bakterien MRSA:
In den ersten Sekunden

Nach 15 Minuten

Nach 2 Stunden
Zudem wurde die Hautverträglichkeit unserer Beschichtung dermatologisch mit sehr gut von DERMATEST® bestätigt und hat die Prüfung nach Spielzeugnorm (DIN EN 71-3) bestanden!
Funktionsweise
Die Beschichtung besitzt bis zu drei hervorragende funktionelle Eigenschaften:
Die porendichte Oberfläche verhindert, dass Viren mit Hüllen wie Influenza und Corona hineindiffundieren können.
Die spezielle Oberflächenspannung sorgt dafür, dass die hydrophilen Membranen der Virushülle nicht an der Oberfläche anhaften können.
Biologisch aktive Verbindungen greifen die Virenhülle an. Dadurch wird die Virenhülle porös und die Viren sterben ab.
Anwendungsbereiche
Die Beschichtung ist in fast allen Lebensbereichen und auf vielen Oberflächen aus Holz, Metall und viele Kunststoffe einsetzbar. Gerne helfen wir Ihnen weiter, wenn Sie zu den Einsatzmöglichkeiten Fragen haben.
ANWENDUNG
1. Sicherheit
Schutzmaske, -handschuhe und -brille anziehen. Fenster öffnen und den Raum durchgängig lüften beim Applizieren
2. Reinigung
Je gründlicher die Reinigung desto überzeugender das Ergebnis! Schmutz, Öle und Fette müssen vollständig entfernt werden. Oberflächen mit Alkohol oder Reiniger (Empfehlung: Frosch Spiritus Glas-Reiniger) reinigen.
3. Abkleben
Nicht zu beschichtende Oberflächen wie Schlösser aussparen ggfs. abkleben.
4. Applikation
Bei großen Oberflächen wie Tische, Türen, Theken, etc. empfehlen wir eine Farbwanne mit Abstreifgitter und einen handelsüblichen Fensterwischer mit Mikrofaserbezug
1. Den Lack in die Farbwanne geben
2. Fensterwischer mit Mikrofaserbezug eintauchen und überschüssiges Produkt am Abstreifgitter abstreifen
3. Den Fensterwischer ohne Druck über die Oberfläche ziehen. Fensterwischer dabei immer in dieselbe Richtung ziehen und wenden
Bei kleinen Oberflächen wir Türklinken, Fensterhebel, Schrankgriffe, etc. empfehlen wir ein handelsübliches Mikrofasertuch
1. Bei Türklinken: Schlüsselloch und die Türfläche um die Türklinke herum abkleben
2. Befeuchten Sie den Mikrofasertuch mit dem Lack
3. Wischen Sie damit ohne Druck über die Oberfläche
Idealschichtstärke bei itCoating H 610 N: ca. 20µm und bei itCoating K 620 V und itCoating K 630 N: ca. 5 µm
5. Trocknung
itCoating H 610 N: 20-30 Minuten trocknen lassen. itCoating K 620 V und itCoating K 630 N: 60-90 Minuten trocknen lassen. Mikrofaserbezug/Mikrofasertuch über den Restmüll entsorgen. Fensterwischer, Farbwanne und Abstreifgitter sofort mit Alkohol reinigen.
DAS Coating team
Unsere geschulten und zertifizierten Partner bieten Ihnen ein einzigartiges Hygienekonzept und helfen Ihnen, Ihre Mitarbeiter und Kunden einen optimalen Schutz zu gewährleisten. Wir übernehmen die Organisation, Applikation, Qualitätskontrolle und Dokumentation als Dienstleistung für Sie.
Schulung
Sie möchten die Applikation unserer Produkte selbst übernehmen? Durch unsere Workshops erhalten Sie das notwendige Know-How im Umgang mit unseren Produkten. Nach erfolgreicher Teilnahme erhalten Sie ein Zertifikat, Materialien und exklusiven Zugang zu unserem B2B Shop.
REFERENZEN UND PARTNER
Hygienekonzept der Rudolf Weber Gruppe: Oberflächendesinfektion der Weber Loge, BayArena
Biozidprodukte vorsichtig verwenden. Vor Gebrauch stets Etikett und Produktinformationen lesen.
Technische Merkblätter und Sicherheitsdatenblätter zu den Produkten können über das Kontaktformular angefragt werden.







































































































